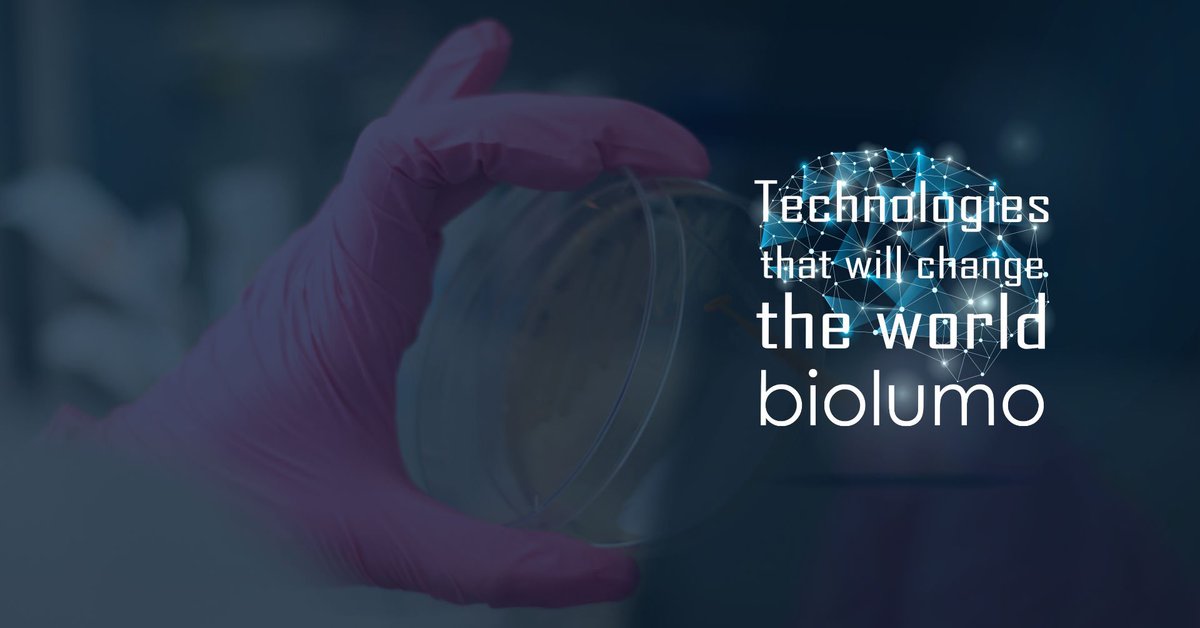
infosharepl tweet media

Biolumo
34 posts


Na #antybiotykooporność tracimy, nie tylko jako #pacjenci, ale też jako podatnicy. Nasz cofounder, @JakubW1990, przeanalizował ile dokładnie. Sprawdźcie na @mamstartup : bit.ly/2DH1ESN
#KeepingAntibioticsWorking #AMR #AntibioticsResistace #EAAD
Polski

Dziś wyjątkowy dzień: Europejski Dzień Wiedzy o Antybiotykach! Z jego okazji przygotowaliśmy raport z badania preferencji lekarzy o diagnostyce infekcji bakteryjnych - dostępny za darmo: bit.ly/2Du9aQJ
#KeepAntibioticsWorking #EAAD #AntibioticResistance
Polski
Biolumo retweetledi

Ich wynalazek w opinii The Journal of mHealth ma być jednym ze 100, które zmienią światową medycynę. Przeczytajcie o @biolumo forbes.pl/biznes/biolumo… #Forbes #nauka
Polski
Biolumo retweetledi

18.11 – Europejski Dzień Wiedzy o Antybiotykach! Z tej okazji Adam zachęca Was do rozważnego ich stosowania oraz daje Wam pigułkę wiedzy o antybiotykooporności!
youtube.com/watch?v=Fx8gAh…
#KeepAntibiotcsWorking #AntibioticAwarenessWeek #AntibioticResistance

YouTube
Polski

Our CEO #Olga_Grudniak has been selected by @Insightscare as one of the Top 20 Most Influential #Leaders in #healthcare 2018!
Insights care@Insightscare
Revolutionizing #Healthcare by Embracing Innovation and Excellence #Olga_Grudniak @biolumo #Healthcare_Magazine The 20 Most Influential Leaders in Healthcare 2018 insightscare.com/olga-grudniak-…
English
Biolumo retweetledi

Today we're starting series of articles about startups that invented world-changing technologies!
First of them - @biolumo - is a MedTech from @gdansk which invented technology that helps to choose the right antibiotic 💊 and its amount.
infoshare.pl/news/one,66,24…
English

@Biotechtweetuje has a step on us on Twitter with this info ;) We are representing Poland in Best Biotech and Best Newcomer categories at regional finals of @cesawards ! Please vote for Polish teams at: campaign.socialcee.com/campaign/#/cam…
Biotechnologia.pl@Biotechtweetuje
@biolumo w Wielkim Finale Central European Startup Awards! Znamy także ich rywali :) biotechnologia.pl/technologie/bi…
English

The most amazing evening for @biolumo! After 3 nominations for @cesawards at today finals at #Impactmobility rEVolution’18 we got... The Best Biotech Startup and The Best Newcomer awards! :)

English
Biolumo retweetledi
Biolumo retweetledi
Biolumo retweetledi

Biolumo: Proffering Reliable and Reasonable Fast Point-of-Care Diagnostic Machine
#Biolumo #Diagnostic #Healthcare #antibiogram @biolumo
insightscare.com/biolumo-proffe…
English

Last call to vote for Polish finalists at Central European Startup Awards! Get to know and support the most promising startups... we are there as well ;) Vote for Biolumo (Best Newcomer, Best Social Impact Startup and Best Biotech Startup): bit.ly/2vPrDSn
English

6 days - you have only 6 days if you are medtech startup and want to participate in the best acceleration program for you... @sbcHealth in Berlin! :)
Check out this short video about our 2017 cohort and SBC itself: youtu.be/HezKtOfffeg

YouTube
English

Our CEO, Olga Grudniak, had a pleasure of pitching today for @RochePolska :) It is nice to see that corporations and startups goes hand-to-hand more often #cooperation #startups #biotech twitter.com/RochePolska/st…
Roche Polska@RochePolska
Dziś w siedzibie @RochePolska Roche #StartUp Day, spotkanie ma na celu wymianę doświadczeń pomiędzy firmą farmaceutyczną, @CampusWarsaw a startup-ami @StethoMeTM @zettagene @biolumo @QuickerSim @InkubatorUW Bioavlee, Genometic, MediShape, Horus, Nightly
English

We had business successes, but this is one major healthcare win! We have been awarded in Healthcare Leader's Competition judged by the most important influencers of #Polish #healthcare :) #AntimicrobialResistance



English

Here’s everything you need to know about this year’s @WolvesSummit #Hardware, #IoT, #FinTech, #Blockchain were among the most debated topics; alumnus @oskarkiwic #CardioCube sweeps away the pitch finals 🏆 and #diversity in tech was a thriving topic! bit.ly/2EHogiB

English

@sbcHealth is open for application! One of the best accelerator there is for #digitalhealth startups - we know it, we are the part of it ;) twitter.com/DarynaKubar/st…
Daryna Kubar@DarynaKubar
The game is on: SBC Digital Health Berlin is accepting applications for 2018! 💪💊🏥 twitter.com/sbcHealth/stat…
English



